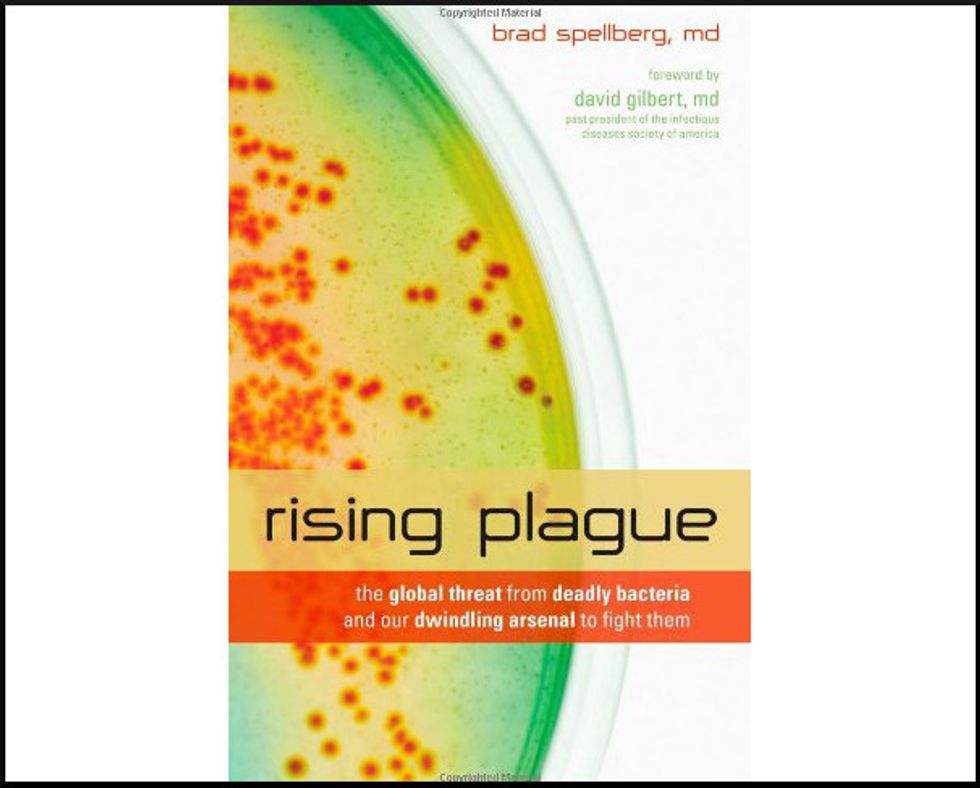
Top Reads For News Junkies: ‘Rising Plague’

In Senate, Manchin Says McConnell Is “Protecting Wall Street,” Not Workers
Reprinted with permission from Alternet
Sen. Joe Manchin (D-WV) called out Senate Majority Leader Mitch McConnell (R-KY) on Monday for being more concerned with propping up financiers than providing supplies to hospitals fighting the novel coronavirus.
“You can throw all the money at Wall Street you want to,” Manchin said after McConnell blamed Democrats for a stalled stimulus bill. “People are afraid to leave their homes. They’re afraid of the health care. I’ve got workers who don’t have masks. I’ve got health care workers who don’t have gowns.”
“And it looks like we’re worried more about the economy than we are the health care and the wellbeing of the people of America,” the West Virginia senator complained.
McConnell interrupted: “The American people are waiting for us to act today! We don’t have time for this! We don’t have time for it!”
“Let me ask you a question,” Manchin implored.
“Answer my question!” McConnell demanded. “In what way would the Democratic Party be disadvantaged?”
“Thirty hours [of debate] or 30 days, as long as you have the votes, 51 votes rule,” Manchin said. “So the final vote is going to be on passage, whether you have to negotiate or not with us.”
“Here’s the way it works!” McConnell exclaimed. “We have been fiddling around as the senator from Maine pointed out for 24 hours…”
At that point, Manchin reclaimed his time, silencing McConnell.
“We just have a little different opinion about this,” Manchin said. “You can’t throw enough money to fix this if you can’t fix the health care.”
“My health care workers need to be protected,” he added. “But it seems like we’re talking about everything else about the economy versus the health care. That doesn’t make any sense to me whatsoever.”
“It seems like we’re more concerned about the health care of Wall Street,” Manchin remarked. “That’s the problem that I’ve had on this.”
Watch the video below from